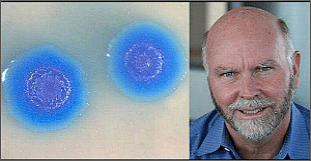

|
Hasta ahora, nadie creó una
célula de la nada, esto es
similar a lo de la oveja Dolly
Crónica
Más allá
de la amplia repercusión mediática que ha tenido un
artículo publicado en la revista Science del
norteamericano Craig Venter sobre la creación de un
nuevo tipo de organismo vivo, muchos genetistas
consideran que el hallazgo de Venter es importante,
pero no supone la creación de vida artificial,
subrayan que en realidad el estudio se basa en
material genético preexistente, pero no supone la
creación de vida artificial.
En
opinión del catedrático español de Biología Celular
y ex presidente del Consejo Superior de
Investigaciones Científicas (CSIC) César Nombela, se
trata de un paso "importantísimo" de la biología
sintética, pero ello no supone la creación de vida
artificial, algo que a su juicio no es posible.
Nombela
precisó que el descubrimiento del equipo de Venter
implica el desarrollo de grandes bloques de genes y
su inserción en una célula, lo que permitirá
plantear organismos de diseño "bastante novedosos".
El investigador incidió en que no se puede hablar
todavía de vida artificial ni de células
artificiales, ya que se trata en cualquier caso de
experimentaciones basadas en células preexistentes.
A su vez
África González, catedrática también española de
Inmunología y actual directora del Centro de
Investigación Biomédica, dice que se ha exagerado al
decir que los investigadores del Instituto Craig
Venter (de California) han creado una célula
artificial. "Nadie hasta ahora ha creado una célula
de la nada",
“Yo lo
asemejaría al de la oveja Dolly, donde se usó el
núcleo de una célula, que se trasplantó a otra y se
desarrolló la oveja, pero no podemos hablar de
ninguna célula artificial, sino de intercambio
genético de una a otra. Lo que ha hecho es
agarrar una bacteria de una especie, sacarle todo el
ADN y pasarlo a otra. Transferir genes es muy
sencillo, la novedad está en la cantidad que ha
metido, en que ha transferido todos los genes que
necesita una bacteria para vivir y que esa nueva
bacteria tiene ahora las características del ADN
donante, convertida en otra especie”.
Ante la
interrogante por qué se maneja como la creación de
la primera célula artificial, González precisa que
“si se analiza el artículo publicado en Sciencie lo
que hacen es aislar genoma donante, preparar a la
que lo va a recibir e instalarlo. Esto ya se ha
hecho, aunque nunca con el genoma entero”… “lo único
que han dicho con este logro es que es posible
modificar todo el genoma de una célula simple, pero
no han construido una célula viva de nada”
El
vaticano habla de “célula artificial”
Por su
parte, el Vaticano mostró cautela ante el anuncio de
la creación de una célula sintética y el portavoz de
la Santa Sede, Federico Lombardi, manifestó ayer que
"es necesario saber más" del tema para expresarse.
"Es necesario esperar, para saber más del caso", se
limitó a decir a la prensa Lombardi, a la vez que el
presidente emérito de la Academia Pontificia para
las Ciencias, el prelado Elio Sgrecia, llamó también
ayer a la cautela.
El
diario vaticano, 'L'Osservatore Romano', en un
artículo del profesor Carlo Bellieni, asegura que se
trata de un trabajo de ingeniería genética "de alto
nivel, un paso más en la sustitución de parte del
ADN". "Pero en realidad no se ha creado vida",
precisó el neonatólogo, que subrayó que se ha
logrado "un resultado interesante, que puede
encontrar aplicaciones y que debe estar regulado,
como todas las cosas que tocan el corazón de la
vida".
Según
Bellieni, la ingeniería genética puede hacer cosas
buenas, pero hay que unir la valentía con la
cautela. Agregó que se puede reconstruir el ADN "y
al mismo tiempo se debe considerar que solo es uno
de los motores de la vida". Bellieni subrayó que el
peso del ADN es grande y que grandes son las
esperanzas puestas en las ciencias genéticas. "No
obstante, el ADN a pesar de un óptimo motor, no es
la vida", aseguró.
La
creación de esa célula artificial supone, según el
jefe de los obispos italianos, el cardenal Angelo
Bagnasco, una nueva "señal" de la gran inteligencia
del hombre. Precisó que la inteligencia y la
responsabilidad van juntas y cualquier forma de
inteligencia debe ser medida teniendo en cuenta la
dimensión ética y la dignidad de la personas.
El
prelado Elio Sgreccia aseguró que no estamos ante la
creación de una célula artificial sino ante la
manipulación del genoma.
Preguntado en 'The Independent' si trata de
suplantar a Dios en la creación de vida, Craig
Venter explicó ayer que eso se dice cada vez que se
produce un importante descubrimiento en las
ciencias, sobre todo en la biología.
Resumiendo
En el
trabajo publicado en la revista Science, el biólogo
estadounidense ha reproducido de forma sintética una
célula habitual que ya existe en la naturaleza. Las
piezas que forman el puzle del genoma bacteriano son
conocidas desde hace años e incluso se venden
comercialmente, por lo que el mérito de Venter no ha
sido fabricarlas. Lo que ha hecho el equipo es
ensamblarlas e introducirlas en otra célula huésped
que había sido desprovista de su información
genética. Como resultado, esta última célula, ya
equipada con el nuevo genoma, adquirió las
características de la primera. En cierta manera, fue
como una clonación, manifiesta Gemma Marfany,
profesora de genética en la universidad de
Barcelona.
Agregando que de hecho, mediante la modificación de
una parte del genoma, hace décadas que se fabrican
bacterias que no existen en la naturaleza. También
hay desde hace años mamíferos transgénicos. En el
experimento difundido por Science, no solo fue
necesaria una segunda célula, la que aportaba el
citoplasma, sino otra de levadura que reconocía las
piezas y las colocaba en correcta posición. Venter
dice que fueron precisos varios intentos porque un
único error, entre millones, impedía el desarrollo.
“No podemos decir que sea artificial al 100%. No
hemos llegado al grado de sapiencia de crear un ser
desde cero”, concluye por su parte Marfany.
Fuente: Agencias y periódicos
Foto: Dr. Craig Venter y Celula
LA
ONDA®
DIGITAL |